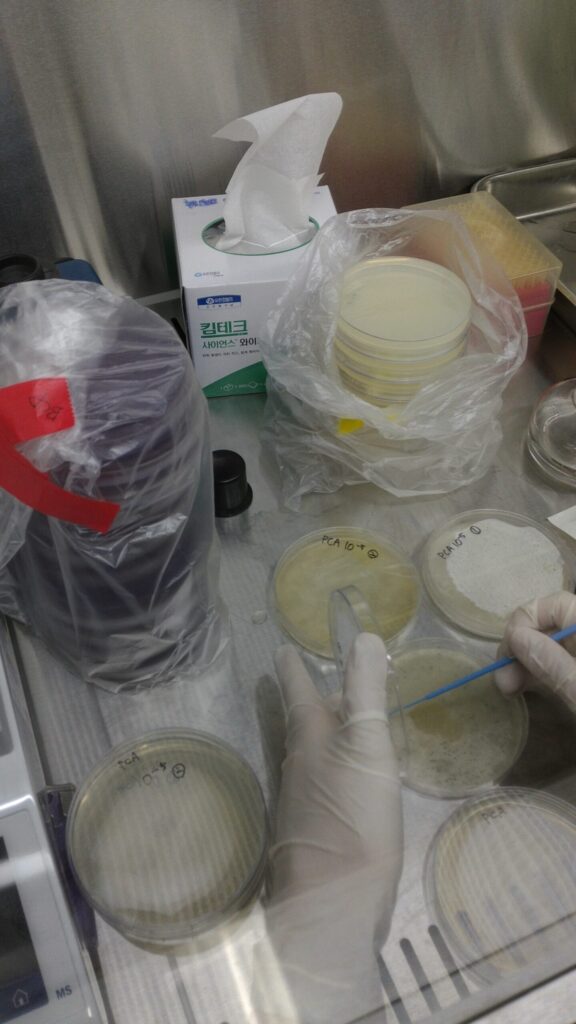
판교 인턴 실험실

생명공학 전공에 ‘영알못’이었던 제가 어떻게 10년 만에 미군부대 KGS 9급이 되었을까요? 결론부터 말씀드리면, 미군부대 취업은 화려한 스펙보다 ‘운’을 실력으로 만드는 ‘현장 경험’과 ‘네트워킹’이 핵심입니다. 밑바닥 KWB 알바에서 시작해 신의 직장이라 불리는 KGS로 올라간 제 실전 루트를 공개합니다.
KWB 2급 골프장 알바: 생존을 위한 처절한 시작

대학교에서 생명공학을 전공하고 경영학을 복수전공했습니다. 대학시절 영어 한마디 못하던 제가 무작정 아이엘츠를 공부해 사우스다코타주 Black hills state university 로 교환학생을 다녀왔습니다. 대학교 4학년 판교 농협 연구원 인턴 생활은 제게 회의감만 안겨주었습니다. 대학교 시절 흑인 교수님이 용산부대 드레곤힐에서 져녁을 사주셨습니다. 그 기억이 너무 인상 깊게 남아 미군부대 취업에 대해 알아보게 되었죠. 대학교 공부와 아무 상관없이 선택한 곳은 성남 미군부대 골프장이었습니다.
- 직급: KWB 2급 (Food Service Worker)
- 근무 환경: 35도 폭염 속에서 골프 카트를 몰며 음료와 간식 판매
- 리스크: 6개월 단기직, 기간 내 이직 못 하면 퇴출되는 배수진의 상황
당시 저는 매일 카트를 몰며 부대 내 공고를 확인했습니다. 미군부대 생태계는 일단 ‘안에 발을 들이는 것’이 무엇보다 중요합니다. 외부인보다 내부 채용 정보가 훨씬 빠르기 때문입니다.
운명을 바꾼 동두천 캠프 케이시 Lodging 면접
직종이 뭔지도 모르고 지원했던 동두천 캠프 케이시의 ‘Lodging(숙박시설)’. 면접장에 들어갔을 때 저는 Lodging이 호텔 업무인지도 몰랐을 만큼 무지했습니다. 하지만 여기서 ‘교환학생 경험’이 빛을 발했습니다.

| 구분 | 내용 |
|---|---|
| 면접관과의 유대감 | 책임자가 제가 다녀온 사우스다코타주 출신 (Ice Breaking 성공) |
| 합격 직급 | KGS 4급 (행정직 전환의 첫 단추) |
| 핵심 전략 | 미국 문화를 이해하고 있다는 공감대 형성이 기술적 영어보다 중요 |
KWB(기능직)에서 KGS(행정직)로의 전환은 하늘의 별 따기라고들 하지만, 저는 현장에서 몸으로 부딪히며 쌓은 태도와 운을 연결해 결국 KGS 4급으로 입성했습니다.
용산 이전과 캠프 험프리스 우체국 KGS 5급 승진
부대 운영은 거대한 흐름이 있습니다. 당시 용산 기지 이전 계획에 맞춰 인력 재배치가 활발했고, 저는 이 기회를 놓치지 않았습니다. 캠프 케이시에서 평택 캠프 험프리스 우체국으로 단체 이직하며 KGS 5급으로 승진하는 행운을 거머쥐었습니다.
미군부대 우체국 업무는 일반 행정과 다릅니다. 미 우편 규정(USPS)과 군사 우편 규정을 숙지해야 하며, 특히 DOD(미 국방부) 안전 규정을 준수하는 것이 최우선입니다. 이 시기 저는 단순히 우편물을 나르는 것이 아니라 시스템을 관리하는 전문가로 거듭났습니다.
결론: 미군부대 취업, ‘스펙’보다 ‘타이밍’과 ‘경험’
10년 전 골프 카트를 몰던 KWB 2급 알바생은 이제 KGS 9급 베테랑이 되었습니다. 미군부대 취업을 희망하신다면 처음부터 높은 곳만 보지 마세요. 일단 부대 내부로 진입(Get your foot in the door)하고, 그 안에서 기회를 엿보는 것이 가장 빠른 지름길입니다.
전문가 한 줄 조언: “완벽한 영어 실력보다 중요한 건, 미군 조직이 신뢰할 수 있는 ‘부대 내 경력’입니다.”
여러분은 현재 어떤 직급으로의 진입을 꿈꾸고 계신가요? 댓글로 고민을 남겨주시면 제 10년 치 노하우를 공유해 드리겠습니다. 다음 글 2탄에서 만나요.
